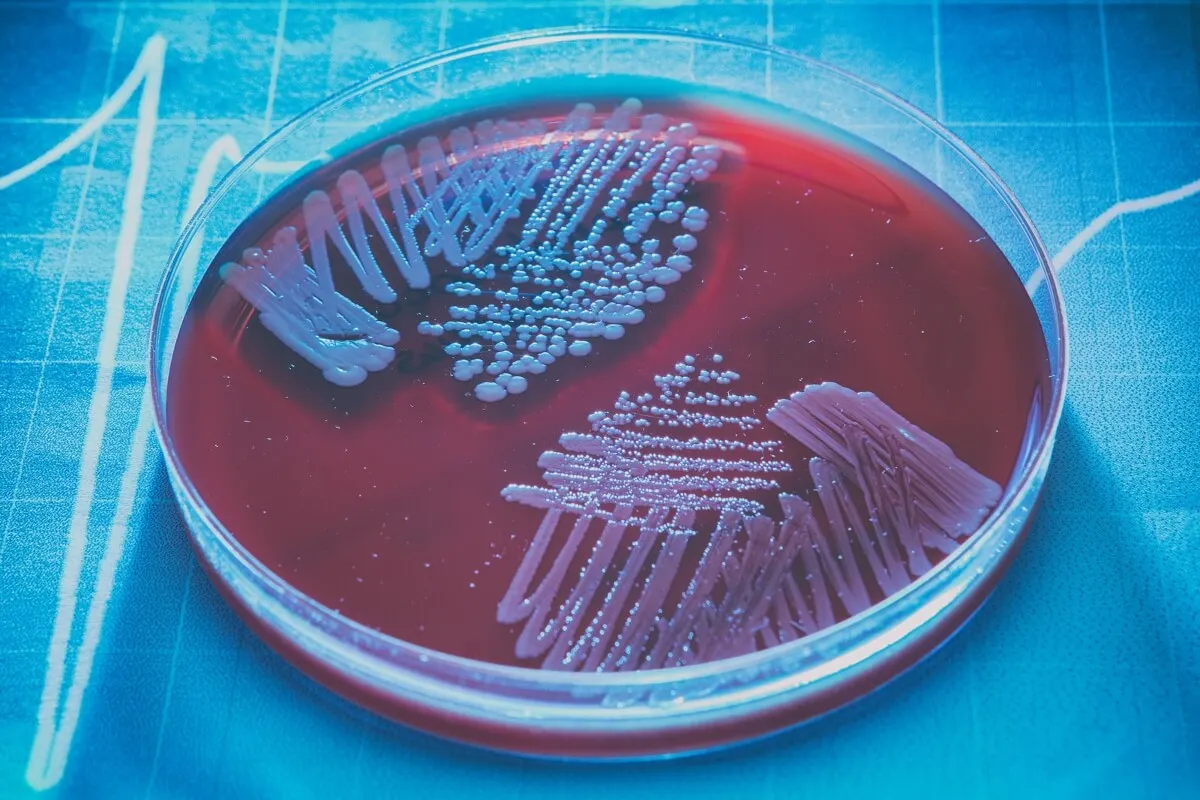

Видове лекарства за цистит: характеристики и противопоказания


Прегледано и одобрено от фармацевт Franciele Rohor de Souza
Циститът е инфекция на долните пикочни пътища, която възниква, когато определени бактерии достигнат пикочния мехур. Тази патология е много досадна и трябва да се лекува възможно най-скоро. Искате ли да знаете за различните видове лекарства за цистит? Тук ще ви разкажем за различните опции.
Проучванията показват, че инфекциите на пикочните пътища са сред най-честите причини за посещение при лекар. Симптомите варират от болка и затруднено уриниране до мътна урина със силна или неприятна миризма.
Ранната диагностика и бързото лечение на това състояние са от решаващо значение за подобряване на прогнозата за здравето. Терапевтичният неуспех или забавянето на професионалния подход благоприятства появата на усложнения в средносрочен и дългосрочен план.
5 вида лекарства за цистит
Лечението на цистит е насочено към елиминиране на отговорните бактерии и от своя страна облекчаване на дискомфорта. Изборът на лекарство за цистит ще зависи от това дали е остра или хронична инфекция. Терапевтичните възможности включват следното:
1. Антибиотици
Това са лекарствата първи избор при цистит, тъй като те са отговорни за унищожаването на причинителя. Според проучвания микроорганизмите, които най-често причиняват инфекции на пикочните пътища, са тези, които обитават стомашно-чревния тракт, като Escherichia coli. Някои от антибиотиците, ефективни срещу тези бактерии, са следните:
- Фосфомицин: Това е едно от лекарствата, използвани за лечение на инфекции на пикочните пътища. Препоръчителната доза е 1 саше от 8 грама наведнъж или на всеки 24 часа в продължение на 2 дни.
- Нитрофурантоин: Нитрофурантоинът е друго ефективно лекарство за цистит. Дозировката обикновено е 1 капсула от 100 милиграма на всеки 6 часа в продължение на 7 до 10 дни. Подобно на фосфомицин, нитрофурантоинът има минимален ефект върху нормалната чревна флора, според изследвания.
- Триметоприм-сулфаметоксазол: Това е смес от 2 фармакологични съединения, които са особено ефективни срещу Escherichia coli и други ентеробактерии. Дозировката му обикновено е 1 или 2 таблетки на всеки 12 часа, в продължение на поне 5 дни.
- Пеницилини и цефалоспорини: Това са съединения, които действат чрез инхибиране на образуването на стената, която покрива бактериите. Тяхната дозировка е различна за всяка група лекарства. Някои използвани пеницилини са ампицилин и амоксицилин с клавуланова киселина.
- Флуорохинолони: те не се използват често при неусложнени инфекции на пикочните пътища, тъй като в повечето случаи рисковете надвишават ползите. Офлоксацин, ципрофлоксацин и левофлоксацин са едни от най-ефектевните.
Противопоказания
Основното противопоказание за приемане на антибиотични лекарства при цистит е алергия към активната съставка, особено към пеницилин. Приемът на тези лекарства от алергични лица може да причини животозастрашаваща генерализирана възпалителна реакция.
Освен това бременните или кърмещите жени трябва да се консултират предварително със специалист, тъй като те могат да повлияят на бебето. Деца под 3-месечна възраст и хора с бъбречни заболявания трябва да получават специални дози.

2. Лекарства за цистит – спазмолитици и аналгетици
Болката и паренето по време на уриниране обикновено са най-досадните симптоми на цистит. Други симптоми, които причиняват дискомфорт, са позиви за уриниране, коремна болка и повишена честота на уриниране. За щастие, лекарствата за цистит включват спазмолитици и болкоуспокояващи.
Спазмолитици, като скополамин и флавоксат, помагат за облекчаване на симптомите. И двете предотвратяват свиването на пикочния мехур, което намалява болката и честотата на уриниране.
Феназопиридинът е аналгетик, който действа върху пикочните пътища, така че е в състояние да облекчи болката при цистит. Всъщност проучване в списанието Urologia показа, че това е полезно лекарство и се понася добре от хора с неусложнен цистит.
Противопоказания
И скополаминът, и флавоксатът са противопоказани при обструктивни уринарни патологии, както и при пилорна обструкция и паралитичен илеус. Това е така, защото те намаляват естествената перисталтика и влошават тези патологии. Скополаминът е противопоказан и при миастения гравис и закритоъгълна глаукома.
Феназопиридинът е противопоказан при деца под 12-годишна възраст. Освен това трябва да се използва с изключително внимание при хора с чернодробни или бъбречни заболявания.
3. Антисептици
Други лекарства, полезни при лечение на цистит, са антисептиците. Изследванията ги описват като химични съединения , които се използват върху кожата или лигавиците, за да инхибират бактериалния растеж. В този случай най-често използваните са метенамин и метилтиониниев хлорид.
И двете съединения са способни да елиминират микробите от пикочните пътища, като по този начин облекчават симптомите в рамките на няколко дни. В допълнение, проучванията установяват, че метенаминът често се предписва за предотвратяване на рецидив на цистит в краткосрочен план.
Противопоказания
Метенаминът не трябва да се използва при никакви обстоятелства при хора с тежка чернодробна или бъбречна недостатъчност или при тези с метаболитна ацидоза. Това е така, защото тези клинични картини могат да се влошат и да изложат на риск живота на пациента.
4. Лекарства за цистит – противовъзпалителни лекарства
Нестероидните противовъзпалителни средства (НСПВС), като ибупрофен, се използват за лечение на дискомфорта от цистит на първо място, според проучвания. Благодарение на механизма си на действие те намаляват възпалението в пикочния мехур, което облекчава болката и паренето при уриниране.
Ефективността на тези съединения може да се увеличи, когато се приемат заедно със спазмолитици, като скополамин. Както бе споменато по-горе, последното ще намали контракциите на пикочния мехур и уретрата, осигурявайки допълнително облекчение.
Противопоказания
Противовъзпалителните лекарства са безопасни за повечето хора. Употребата им е противопоказана само при пациенти, които са имали заболявания, свързани с приема им, като бронхоспазъм, уртикария или стомашно-чревно кървене.
5. Ваксини за инфекции на пикочните пътища
Има полезни методи за имунизация за лечение и профилактика на цистит, като случая с Uro-vaxom ®. Това е таблетка, съдържаща повече от 10 щама на Ешерихия коли, която, както вече споменахме, е основният причинител на инфекции на пикочните пътища в световен мащаб.
Лекарството има способността да активира имунната система, за да се бори с колонизацията и инвазията от тези бактерии. Проучване, публикувано в списанието Current Urology, посочва, че това е ефективно лечение за предотвратяване на повтарящи се инфекции на пикочните пътища.
Противопоказания
Ваксината под формата на таблетки е едно от най-безопасните лекарства в целия списък и единственото й противопоказание е алергия към някой от компонентите на лекарството. Приемът трябва да се преустанови, ако се наблюдава някаква кожна реакция, като уртикария, оток или треска.
Ефикасността им при деца под 4-годишна възраст все още не е доказана.
Други лекарства за цистит
Всички лекарства, споменати по-горе, са полезни при остър цистит, но терапевтичните възможности за хронични или повтарящи се случаи могат да варират. Интерстициалният цистит е един от най-тежките варианти, така че подходът трябва да бъде по-агресивен, комбинирайки следните варианти:
- Антихистамини: Те намаляват честотата на уриниране. Едно от лекарствата от тази група е лоратадин.
- Пентозан полисулфат натрий: Смята се, че предпазва вътрешните стени на пикочния мехур от дразнители, въпреки че механизмът му на действие не е напълно разбран. Намалява увреждането на органа и облекчава болката при уриниране.
- Трициклични антидепресанти: Благодарение на афинитета си към множество рецептори, те отпускат пикочния мехур и блокират болката, осигурявайки облекчение. Използваните в този случай лекарства са амитриптилин и имипрамин.
Някои препоръки и домашни средства
Възможно е да се приложат някои промени в начина на живот, за да се намали дискомфортът, свързан с цистита. Някои препоръки са следните:
- Пиене на много вода
- Ограничаване на консумацията на дразнещи напитки, газирани напитки и лимонени сокове.
- Избягване на кафе и алкохол.
- Използване на топли компреси в долната част на корема за облекчаване на налягането на това ниво.
В допълнение, има някои домашни средства, които могат да бъдат полезни за предотвратяване и контрол на това състояние. Въпреки това е важно да се подчертае, че те не са заместител на предписаните от лекаря лекарства за цистит.
Проучване, публикувано в The Journal of Nutrition, показва, че консумацията на червени боровинки намалява вероятността от инфекции на пикочните пътища с до 26%.
Билковите чайове, от глухарче и магданоз, са доказано ефективни. Те имат диуретични свойства, така че помагат за предотвратяване на колонизацията на бактерии в пикочните пътища.
Много опции за едно и също състояние
Както можете да видите, има много видове лекарства за цистит. Повечето от тях са насочени към елиминиране на причинителя. Съществуват обаче и съединения, използвани за намаляване и облекчаване на симптомите.
Преди да използвате някоя от опциите, за които ви разказваме, винаги е препоръчително да посетите специалист. Медицинският персонал ще може да идентифицира причинителя и да назначи подходящо лечение.
Всички цитирани източници бяха добре прегледани от нашия екип, за да се гарантира тяхната качествена, надеждна, актуална и валидна информация. Библиографията на тази статия бе считана за надеждна и отговаряща на академичните или научни изисквания.
- Artero, A., Lopéz-Cruz, I., Piles, L., Alberola, J., Eiros, J., Salavert, S., Madrazo, M. (2023). Fluoroquinolones Are Useful as Directed Treatment for Complicated UTI in a Setting with a High Prevalence of Quinolone-Resistant Microorganisms. Antibiotics, 12(1): 183. https://www.ncbi.nlm.nih.gov/pmc/articles/PMC9854898/
- Brodie A., El-Taji O., Jour I., Foley C., Hanbury D. (2020). A Retrospective Study of Immunotherapy Treatment with Uro-Vaxom (OM-89®) for Prophylaxis of Recurrent Urinary Tract Infections. Current Urology, 14(3):130-134. https://pubmed.ncbi.nlm.nih.gov/33224005/
- Díaz, D., Espinoza, L., Madrid, A., Pizarro, P., Chamy, R. (2018). Isolation and Identification of Compounds from Bioactive Extracts of Taraxacum officinale Weber ex F. H. Wigg. (Dandelion) as a Potential Source of Antibacterial Agents.
- Evidence-Based Complementary and Alternative Medicine; 2018: 2706417. https://www.ncbi.nlm.nih.gov/pmc/articles/PMC5817818/
- Jiménez, J., Carballo, K., Chacón, N. (2017). Manejo de infecciones del tracto urinario. Revista Costarricense de Salud Pública; 26(1). https://www.scielo.sa.cr/scielo.php?script=sci_arttext&pid=S1409-14292017000100001
- Kolman K. (2019). Cystitis and Pyelonephritis: Diagnosis, Treatment, and Prevention. Primary Care, 46(2):191-202. https://pubmed.ncbi.nlm.nih.gov/31030820/
- Lee B., Bhuta T., Simpson J., Craig J. (2012). Methenamine hippurate for preventing urinary tract infections. Cochrane Database of Systematic Reviews, (10). https://www.cochrane.org/es/CD003265/RENAL_metenamina-para-la-prevencion-de-las-infecciones-urinarias
- Petrov S., Slesarevskaya M., Chibirov K., Topuzov M., et al. (2020). Efficiency and safety of phenazopyridine for treatment of uncomplicated urinary tract infection: results of multi-center, randomized, placebo-controlled, clinical study. Urologiia, 3:15-21. https://pubmed.ncbi.nlm.nih.gov/32597580/
- Tan, C., Chlebicki, M. (2016) Urinary tract infections in adults. Singapure Medical Journal; 57(9): 485–490. https://www.ncbi.nlm.nih.gov/pmc/articles/PMC5027397/
- Urology Care Foundation (2023) Interstitial Cystitis. Consultado el día 12 de julio de 2024. https://www.urologyhealth.org/urology-a-z/i/interstitial-cystitis
- Xia, J., Yang, C., Xu, D., Xia, H., Yang, L., Sun, G. (2021). Consumption of cranberry as adjuvant therapy for urinary tract infections in susceptible populations: A systematic review and meta-analysis with trial sequential análisis. Plos One; 16(9): e0256992. https://journals.plos.org/plosone/article?id=10.1371/journal.pone.0256992
- Yu, Z., Jian-Guo, W., Hong-Ji, Z., Wen-Xiang, H., Bei, J. (2020). Efficacy of Nonsteroidal Anti-inflammatory Drugs for Treatment of Uncomplicated Lower Urinary Tract Infections in Women: A Meta-analysis. Infectious Microbes & Diseases; 2(2):p 77-82. https://journals.lww.com/imd/fulltext/2020/06000/efficacy_of_nonsteroidal_anti_inflammatory_drugs.7.aspx
Този текст се предоставя само с информационна цел и не замества консултация с професионалист. При съмнения, консултирайте се със своя специалист.







